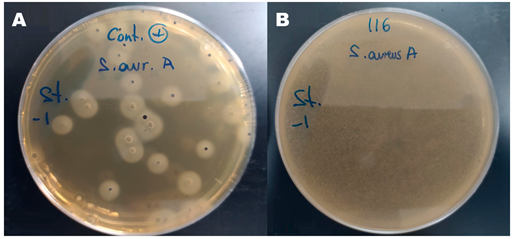

eISSN: 2379-6367


Research Article Volume 11 Issue 5
1Hospital Universitari Dexeus - Paidodex, Dermatologist, Spain
2Hospital Universitari Dexeus - Paidodex, Pediatrician, Spain
3Medichem, Pharmaceutical Development Scientist, Spain
Correspondence: Isabel Fernández, Medichem Pharmaceutical Development Scientist, Barcelona, Catalonia, Spain
Received: November 21, 2023 | Published: December 1, 2023
Citation: Castany A, Gairí JM, Fernández I. Antimicrobial properties and skin compatibility of a new emollient (body lotion) containing octenidine and silver citrate for atopic skin. Pharm Pharmacol Int J. 2023;11(5):170-174. DOI: 10.15406/ppij.2023.11.00417
Introduction: Emollients are the mainstay of nonpharmacologic treatment of atopic dermatitis and are considered critical in the care of skin with an atopic tendency to prevent the appearance of cutaneous symptoms. Its function is to improve hydration and restore skin barrier function, whose alteration leads to transepidermal water loss and facilitates excessive colonization by Staphylococcus aureus (S. aureus). We are presenting the first trials conducted with a new cosmetic emollient product containing octenidine and silver citrate as antimicrobial components.
Material and methods: The following have been evaluated: in vitro antimicrobial capacity of the product against S. aureus, skin compatibility in subjects with sensitive skin (patch-test) and antimicrobial protection of the product (Challenge test).
Results: In vitro studies demonstrated inhibition of S. aureus growth. After 48 hours of contact with the product under an occlusive patch, none of the subjects showed any signs of irritation. The effectiveness of the product’s preservative system was confirmed in the Challenge test.
Conclusions: The new cosmetic containing octenidine and silver citrate, specially designed for skin with an atopic tendency, thanks to its emollient and antimicrobial effect, has been shown to be effective for controlling the bacterial overgrowth of S. aureus characteristic of AD, without being an irritant and with good skin compatibility.
Atopic dermatitis (AD) is a chronic, relapsing, pruritic inflammatory skin disease that follows a recurrent course.1 AD is the most common chronic inflammatory skin disease. It generally begins in early childhood but often persists for life, especially in its moderate-to-severe form;2 and in fact, evidence suggests that the prevalence of persistent and new cases in adulthood is increasing. The irritating, pruritic and cosmetically significant nature of the disease can profoundly affect the quality of life of patients and their relatives, involving both psychological factors (mood and self-esteem) and social and functional factors (daily relationships and activities).3 Its pathophysiology is complex and includes disruption of skin barrier function, immune dysregulation, genetic susceptibility, and environmental factors; making it difficult to find an effective treatment.2,4-6
The alteration of the skin barrier is one of the main factors in the development of the disease, since it reduces skin hydration and facilitates excessive colonization by Staphylococcus aureus causing an imbalance of the skin microbiota. Decreased expression of skin barrier proteins and enzymes involved in the formation of the natural humectant factor entail decreased levels of certain substances, such as sphingosine and hexadecanoic acid, which act as natural antimicrobials. As a result, the skin is more susceptible to colonization by S. aureus.7-9
S. aureus colonization density has been shown to be correlated with disease severity.10 Exotoxin and superantigen production is related to the development of outbreaks and worsening of clinical symptoms.11,12 In addition, staphylococcal biofilm formation also plays an important role in the occlusion of sweat ducts, leading to inflammation and pruritus.13 Despite this, antimicrobial therapy with antibiotics is not recommended in the treatment guidelines as standard treatment for AD, except in cases where lesions show clear clinical signs of superinfection (drainage, crusts and pustules), due to the risk of developing resistance. In contrast, they do suggest the use of topical antiseptics, mainly in patients with a history of recurrent skin infections.14
The study product is a new cosmetic skin care product (body lotion) that includes different types of emollients, some more hydrophilic (such as glycerin) found in the aqueous part of the formulation and that provide an immediate hydrating effect, and others with a more lipophilic effect, such as Caprylic/Capric Triglyceride, which are found in the oily phase of the formulation and act to create a film on the skin and between the corneocytes that prevents transepidermal water loss.
In addition to emollients, the new product includes, as main active ingredients, octenidine and silver citrate, both with antimicrobial activity. Octenidine is a topical antiseptic known since the 1980s with a broad antimicrobial spectrum against a wide range of Gram-positive and Gram-negative bacteria, including methicillin-resistant S. aureus (MRSA). This molecule has no cutaneous or mucosal absorption, so it shows no systemic toxicity and is used in a wide range of preparations for antisepsis at sites such as the skin, mucous membranes or oral cavity, and it can also be applied to wounds.15,16 There are no studies on the use of this compound prior to conception or in pregnant or breastfeeding women with AD. However, it has been used to treat vaginal dysbiosis during pregnancy, which has allowed the successful prevention of premature birth without causing birth defects, so it can be considered a safe product for this group.17 The use of elemental silver and silver salts as antibiotics has been known in human healthcare for a long time.18 Their antimicrobial action depends on the bioavailability of the silver ion (Ag+),19,20 which, in the case of silver citrate, is high, giving it a rapid antimicrobial effect that makes it suitable for inclusion in skin care formulations.19,20 Modern tissues with silver show potential in reducing the severity of dermatitis and the burden of Staphylococcus aureus, but others still need further research.21 The combination of silver and octenidine is employed due to the unique and complementary antimicrobial properties of each compound. Octenidine acts as an immediate antimicrobial agent, effectively eliminating a broad spectrum of pathogens upon contact. However, it is typically used at low concentrations to minimize potential cytotoxic effects. On the other hand, silver, while not as immediately active, provides a sustained antimicrobial effect. This prolonged action allows for continued protection against microbial colonization and biofilm formation over time. Therefore, the combination of these two agents - the immediate action of octenidine and the sustained effect of silver - provides a comprehensive and enduring antimicrobial strategy, making them a potent pair in combating infections.
In addition to antimicrobial agents, the product contains Laureth-9 and chamomile extract. Laureth-9, also known as polidocanol (CAS 9002-92), is a polymer used as an emulsifier and surfactant in cosmetics like bubble baths, shampoos and cleaning products.22 Polidocanol possesses local anesthetic properties, and it is used as an antipruritic agent in galenic formulations and cosmetic products for the treatment of skin conditions associated with itching, such as eczema.23 Chamomile (Matricaria recutita L.), belonging to the Asteraceae family, contains three main sesquiterpene constituents (azulene, bisabolol and farnesene) with antiinflammatory, analgesic, antioxidant, mildly astringent, healing and antibacterial properties. It is therefore suitable for the treatment of skin disorders such as eczema.24,25
We are presenting the results of the first trials conducted with the new emollient cosmetic product. The objective was, on the one hand, to confirm the in vitro antimicrobial activity of the formulation against bacterial growth of microorganisms, particularly against S. aureus, and on the other hand to verify the skin compatibility of the new formulation containing octenidine and silver citrate, especially for people with atopic-prone skin.
Two types of experiments were conducted in the initial phase of development of the new product. On the one hand, an in vitro study was performed to verify the antimicrobial effect of the formulation against S. aureus and, on the other hand, a skin compatibility study was performed to verify the absence of irritative potential of the formula (Patch-test). Finally, antimicrobial protection of the cosmetic product has been evaluated (Challenge test).
In vitro antimicrobial effect study
An in vitro trial was performed to confirm the preservation of the antimicrobial efficacy of the active agent’s octenidine and silver citrate, after being formulated with the other ingredients in the cosmetic product.
A coagulase-positive Staphylococci count test was conducted according to UNE-EN ISO 6888-2. The medium used was Baird-Parker agar together with a rabbit plasma fibrinogen supplement for the distinction of coagulase-positive colonies, whose primary strain is S. aureus. For the tests, the sample of the product was prepared by adding the diluent at a 1/10 ratio. A dilution bank was prepared and seeding was prepared on 1 mL of the S. aureus inoculum. Baird-Parker agar was added to the inoculated plates and they were incubated at 37°C in aerobiosis for 24-48h. The inoculum used was approximately 400-500 cfu/g to obtain statistically reliable counts. A total of 3 types of controls were performed: negative control (diluent only), blank control (product only), and positive control (inoculated bags without product). Finally, the colony count was performed on the plates and the corresponding calculation was performed taking into account the inoculum volume and dilutions of the count.
Skin compatibility study (patch-test)
A patch-test was performed to verify the good skin compatibility of the cosmetic investigational product with healthy adult volunteer subjects with sensitive skin, defined as a recent and repeated history of functional symptoms of skin discomfort (e.g., tingling, burning or stinging, pruritus, reddening, etc.). A single product application (0.02 g over an area of 50 mm²) was performed on the skin of the back (area without nevi, redness or skin changes) under an occlusive patch that was maintained for 48 hours. The clinical assessment was performed by a dermatologist approximately 30 minutes after removal of the occlusive patch and compared to the “negative” control consisting of a patch without product. Skin irritation was quantified by the dermatologist according to a defined numerical scale (4- or 5-point Likert-type scales) for each of the following skin signs: erythema (0-4), edema (0-3), papule/vesicles/bullae/pustules (0-4), dryness/desquamation (0-4), detergent effect/roughness (0-4), and reflectivity/shine (0-4). The evaluations were performed by the difference from control method (product – control). At the end, the Primary Dermal Irritation Index (PDII) was determined considering as such the mean of the weighted sum of evaluations obtained in all subjects, according to the following weighting factors: (erythema) factor 1, (edema, papule, vesicle, blister, pustule) factor 2 and (dryness, detergent effect, reflectivity) factor 0.5.
Antimicrobial protection test (challenge test)
A Challenge test was performed to evaluate the preservation of the cosmetic formula against the inoculation of microorganisms. The experiment was performed with standardized inocula of Pseudomonas aeruginosa (ATCC 9027), Staphylococcus aureus (ATCC 6538), Escherichia coli (ATCC 8739), Candida albicans (ATCC 10231) and Aspergillus brasiliensis (ATCC 16404). A neutralizing agent was used to neutralize the inhibitory substances present in the product sample, whose efficacy was verified prior to inoculation. The amount of 108 cfu/ml of bacteria or 106 to 108 cfu/ml of C. albicans and A. brasiliensis were inoculated, each on a sample of 20 g of the product (as established by the ISO 11930:2019 regulations) that was protected from light at a room temperature of 20-25°C. Bacterial growth controls were performed at 8, 14, and 28 days, where the number of surviving organisms was assessed by the plate seeding protocol. For each time and strain, the log reduction value was calculated and compared to the minimum values required for the evaluation criteria. The criteria established by standard ISO 11930 for the Assessment of Antimicrobial Protection of a Cosmetic Product were used as the criterion for the efficacy of the product’s preservative system against colonization by microorganisms.
In vitro antimicrobial effect
The negative (diluent) and blank (product only) controls showed no coagulase-positive colony overgrowth. The positive control (bags inoculated without product) showed a plate count after incubation at 37°C between 108% and 111% for S. aureus. In contrast, the inoculated product samples had a post-incubation plate count of less than 10% for S. aureus (Figure 1).
Figure 1 In vitro antimicrobial effect. A) Positive control plate after 48 hours of anaerobic incubation at 37ºC; B) Inoculated product plate after 48 hours of anaerobic incubation at 37ºC.
Skin compatibility study (patch-test)
A total of 14 subjects were recruited for this study, of whom only 10 reported to the laboratory on the day of the appointment to undergo the test. The 10 healthy volunteer subjects (males and females), aged 18 to 70 years, had a history of sensitive skin, of which 2 subjects reported a history of skin with an atopic tendency. After 48 hours in contact with the product under the occlusive patch, none of the subjects showed any signs of irritation. The score for all signs assessed by the dermatologist was zero and the Primary Dermal Irritation Index was also 0.00 (Table 1).
|
Cutaneous irritation quantification |
0 absence |
1 |
2 |
3 |
4 |
Weighting |
|
Erythema |
10 |
0 |
0 |
0 |
0 |
1 |
|
Edema |
10 |
0 |
0 |
0 |
- |
2 |
|
Papulae/vesicles/bullae/pustules |
10 |
0 |
0 |
0 |
0 |
2 |
|
Dryness/desquamation |
10 |
0 |
0 |
0 |
0 |
0.5 |
|
Detergent effect |
10 |
0 |
0 |
0 |
0 |
0.5 |
|
Reflectivity |
10 |
0 |
0 |
0 |
0 |
0.5 |
|
Other abnormality |
10 |
0 |
0 |
0 |
0 |
|
Table 1 Cutaneous irritation quantification after 48h occlusive application of the product to the skin
Primary cutaneous irritation index (P.C.I. #) = 0.000
Antimicrobial protection test (challenge test)
All experiments met the criteria for log reduction of surviving organisms at the established times. The log reduction at 8 days, 14 days and 28 days was 5.39 at all times for P. aeruginosa, 5.28 for S. aureus, between 5.18 and 4.88 for E. coli, from 4.59 to 3.59 for C. albicans and from 4.88 to 3.88 for A. brasiliensis (Figure 2), thereby satisfying criterion A established according to ISO 11930 that demonstrates the effectiveness of the product’s preservative system.
The results of the studies performed have shown that the new emollient product (body lotion) containing octenidine and silver citrate provides a positive antimicrobial effect against S. aureus, the main agent related to the triggering of outbreaks and worsening of the symptoms of atopic dermatitis, having shown a very good tolerability and skin compatibility in adult subjects with sensitive skin, with a Primary Dermal Irritation Index equal to zero. The product has also been shown to meet the requirements for preservation of the formula against colonization by microorganisms.
The treatment guidelines consider emollients essential in the care of skin with atopic tendencies to prevent the appearance of skin symptoms, and also recommend emollients as the basis for non-pharmacological treatment of atopic dermatitis.14
The most characteristic sign of atopic skin is dryness or xerosis, which occurs as a result of altered skin barrier function. The alteration of the skin barrier structure leads to the loss of water through the cornea of the skin, resulting in a greater degree of dryness of the skin, which may lead to symptoms such as pruritus, as well as the initiation of an inflammatory response and the development of eczematous lesions. In turn, the decrease in the formation of the natural humectant factor makes the skin more susceptible to colonization by S. aureus7-9and promotes superinfection of the lesions, particularly in the case of scratching lesions.
S. aureus is considered to be one of the most important factors directly related to the extent and severity of AD. Colonization by S. aureus may result in the formation of biofilms and the secretion of exotoxins and superantigens that stimulate the immune and inflammatory response, even when there are no clear signs of infection.14
However, there is no standard intervention to reduce the burden of S. aureus in AD.26 However, treatment guidelines suggest the use of topical antiseptics that help reduce the burden of staphylococci on the skin rather than antibiotics due to the risk of developing resistant organisms. Some of the strategies used to reduce the burden of S. aureus include bleach baths27 or the use of functional silver- or chitosan-coated antibacterial tissues.28 However, studies on the efficacy of these therapeutic measures, although they suggest a positive effect on microbial burden and skin symptoms, are small and quite heterogeneous, so the evidence is still weak and does not allow for firm recommendation in therapeutic guidelines.29
With the same aim of reducing the burden of S. aureus on atopic-prone skin, the new emollient containing octenidine and silver represents a new option that combines two therapeutic measures in one: the application of a topical antiseptic to the skin and use of an emollient for daily skin care.
The use of octenidine as an antiseptic agent has been widely studied. Its main uses include body washes for disinfection and prevention of (especially nosocomial) infections;30 disinfection of surfaces and surgical material;31 wound healing via impregnated dressings and bandage;32 its use in dentistry as mouthwashes33 for the treatment of gingivitis and other oral infections;34 and its application for the treatment of vaginal infections.35 However, no studies have been found on its use as a topical antiseptic to control overgrowth of S. aureus in skin with eczema or with an atopic tendency to prevent and reduce skin symptoms.
The main novelty of the emollient studied is the inclusion of antiseptic active ingredients despite being a cosmetic for daily care, not specifically designed for the treatment or prevention of infections, wound healing or prevention of nosocomial infections. In contrast, the main purpose of the product is the reduction and prevention of inflammatory response and skin symptoms secondary to alteration of the skin barrier and expression of exotoxins and superantigens of S. aureus.14 The results obtained show that the combination of octenidine and silver citrate with the other components in the emollient product maintains its antimicrobial efficacy against S. aureus. In addition, the patch-test shows very good skin compatibility in subjects with sensitive skin, which is relevant considering its octenidine concentration of 0.15% (higher than the usual 0.1% of other marketed products used in published studies).
Emollients generally contain a humectant agent (which promotes stratum corneum hydration) and an occlusive agent (which reduces evaporation).14 The product studied combines both types of compounds. On the one hand, it contains aqueous phase components such as glycerin that provide an immediate humectant effect and on the other, oily emollients that reach deeper areas of the stratum corneum and create a film on the skin and between the corneocytes that prevents water from evaporating, providing a more sustained feeling of hydration over time. In addition to moisturisers, it also includes among its active ingredients polidocanol, with an antipruritic effect, and chamomile extract with a soothing effect against irritation, both relevant components considering that the product has been specifically designed for the daily care of atopic-prone skin.
The new cosmetic containing octenidine and silver citrate, specially designed for skin with an atopic tendency, thanks to its emollient and antimicrobial effect, has been shown to be effective for controlling the bacterial overgrowth of S. aureus characteristic of AD, without being an irritant and with good skin compatibility.
None.
Authors declare that there is no conflict of interest.

©2023 Castany, et al. This is an open access article distributed under the terms of the, which permits unrestricted use, distribution, and build upon your work non-commercially.